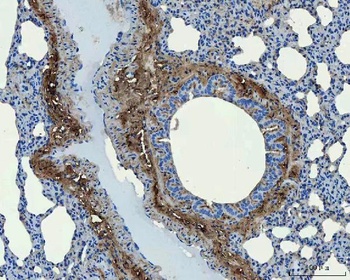
Collagen I/COL1A1 Antibody

You have no items in your shopping cart.
Collagen Type I Antibody
Description
Images & Validation
−| Tested Applications | DOT, ELISA, FLISA, IHC, IP, WB |
|---|---|
| Dilution range | ELISA: 1:5,000 - 1:50,000, FLISA: 1:100, IHC: 1:50 - 1:200, IP: 1:100, WB: 1:1,000 - 1:10,000 |
| Reactivity | Bovine, Human, Mouse, Porcine, Rat |
| Application Notes |
Key Properties
−| Antibody Type | Primary Antibody |
|---|---|
| Host | Rabbit |
| Clonality | Polyclonal |
| Isotype | IgG |
| Immunogen | Collagen Type I from human and bovine placenta |
| Purity | COLLAGEN I Antibody has been prepared by immunoaffinity chromatography using immobilized antigens. Some class-specific anti-collagens may be specific for three-dimensional epitopes which may result in diminished reactivity with denatured collagen or formalin-fixed, paraffin embedded tissues. This antibody reacts with most mammalian Type I collagens and has expected cross-reactivity with Type III and negligible cross reactivity with Type II, IV, V or VI collagens. Non-specific cross-reaction of anti-collagen antibodies with other human serum proteins or non-collagen extracellular matrix proteins has not been tested. |
| Conjugation | Unconjugated |
Storage & Handling
−| Storage | Store vial at 4° C prior to opening. This product is stable at 4° C as an undiluted liquid. Dilute only prior to immediate use. For extended storage, mix with an equal volume of glycerol, aliquot contents and freeze at -20° C or below. Avoid cycles of freezing and thawing. |
|---|---|
| Form/Appearance | Liquid (sterile filtered) |
| Buffer/Preservatives | 0.01% (w/v) Sodium Azide |
| Concentration | 1.06 mg/mL |
| Disclaimer | For research use only |
Alternative Names
−Similar Products
−Collagen Type I Antibody [orb345343]
DOT, ELISA, FLISA, IHC, IP, WB
Bovine, Human, Mouse, Porcine, Rat
Rabbit
Polyclonal
Unconjugated
100 μgCollagen Type I Antibody [orb345345]
DOT, ELISA, FLISA, IHC, IP, WB
Bovine, Human, Mouse, Porcine, Rat
Rabbit
Polyclonal
Unconjugated
25 μlSCARB1/Scavenger Receptor BI Recombinant Rabbit Monoclonal Antibody [orb1499402]
ICC, IF, IHC-Fr, IHC-P, WB
Mouse, Rat
Human, Mouse, Rat
Rabbit
Recombinant
Unconjugated
25 μl, 50 μl, 100 μlCollagen I/COL1A1 Antibody [orb107158]
ICC, IF, IHC, WB
Human, Mouse, Rat
Rabbit
Polyclonal
Unconjugated
100 μg

Quality Guarantee
Explore bioreagents carefree to elevate your research. All our products are rigorously tested for performance. If a product does not perform as described on its datasheet, our scientific support team will provide expert troubleshooting, a prompt replacement, or a refund. For full details, please see our Terms & Conditions and Buying Guide. Contact us at support@biorbyt.com.

ACLP signaling represses adipogenesis. A, Scheme of 10T1/2 adipogenesis and rACLP treatment. B, 10T1/2 fibroblasts were treated with 30 nM rACLP on days -2, -1, 0, +2 and +4 and induced to undergo adipogenesis with DMII on day 0. Protein was harvested on day +6 and analyzed by SDS-PAGE and Western blot with antibodies against ACLP, collagen, Œ±-SMA, AdipoQ, FABP4, PPARŒ≥ and cyclophilin-a (CypA). PPARŒ ≥ analysis was performed in separate experiments. Protein expression was quantified by densitometry normalized to CypA expression and relatively compared to control cells. *, p < 0.05 versus control, one sample t-test for all values. C, 10T1/2 fibroblasts were treated with 30 nM rACLP on days -2, -1, 0, +2 and +4 and induced to undergo adipogenesis with DMII on day 0. On day +6 cells were fixed, stained, imaged and quantified with Oil Red O dye (n = 3). Data were normalized relative to untreated controls. *, p < 0.05 versus paired control, one sample t-test. Data presented are expressed as mean ¬± SD. The scale bar represents 2 mm.

Compound 2 suppressed the collagenolytic effect of ColQ1 ex vivo in pig skin tissue. a) Dose-dependent effect of compound 2 quantified by Hyp release assay. b) Confocal SHG images showed an improved COL signal with 5 √ó 10, àí6 m of compound 2 (tissue challenged with 300 √ó 10, àí9 M ColQ1) compared with 300 √ó 10, àí9 M ColQ1 without inhibitor. c) Immunostaining of fibrillar COLs of the non-treated pig skin and treated with ColQ1 with or without compound 2. Statistical analysis was performed with one-way ANOVA and statistical significance was analyzed by Tukey test. Significance was calculated by comparing non-treated versus treated tissue with compound 2 (mean ¬± SD, *** p, â§ 0.001, ** p, â§ 0.01). Hyp: hydroxyproline, COL: collagen, SHG: second harmonic generation. Scale bar: 100 Œºm for SHG images and 100 Œºm for the immunostained images.

Human AF matrix biochemical characterization with herniation progression. A) Histological/IHC staining for a–d: Alcian Blue/Picro-Sirius Red, scale bar: 100 µm; e–h: Collagen I, scale bar: 100 µm; i–l: Collagen II, scale bar: 100 µm; m–p: Fibronectin, scale bar: 100 µm. B) Quantification of each staining per herniation type. Data presented using dot plots, with median and interquartile range. Kruskal-Wallis test followed by corrected Dunn's were performed. *p < 0.05; **p < 0.01. C) Multivariate analysis of interaction of hernia containment level with age for each staining

Immunofluorescence results using Rabbit Anti-Collagen Type I Antibody. hCFs were fixed with 4% paraformaldehyde, and then cells were permeabilized with 0.1% Triton X-100 for 5 min. Samples were blocked with 1% BSA +4% FBS and incubated with the primary antibodies α-smooth muscle actin (SMA) and collagen type I and respective secondary antibodies. Cell nuclei were stained with 4', 6'-diamino-2-fenil-indol (DAPI; 5 µg/ml). (F, G) Representative images and respective quantification of the alpha-smooth muscle actin (α-SMA) and collagen type I (α-COL I) of hCFs cultured in 2% pericardial fluid. Pericardial fluid is a reservoir of fibrosis-related molecules and induces cardiac fibroblast activation.

Immunofluorescence results using Rabbit Anti-Collagen Type I antibody. hCFs were fixed with 4% paraformaldehyde, and then cells were permeabilized with 0.1% Triton X-100 for 5 min. Samples were blocked with 1% BSA +4% FBS and incubated with the primary antibodies α-smooth muscle actin (SMA) and collagen type I and respective secondary antibodies. Cell nuclei were stained with 4', 6'-diamino-2-fenil-indol (DAPI; 5 µg/ml). miR-22-3p overexpression inhibits hCF activation in vitro. (F) Representative figures of α-SMA and COL I in transfected hCFs following a 7-day activation assay. (G) Percentage of α-SMA + cells (n = 4/group) and area of COL I per cell (n = 2/group).

Immunofluorescence staining of extracellular and intracellular type I collagen. (a) Immunofluorescence staining of type I collagen secreted from MEF clones was performed with an anti-type I collagen antibody without cell permeabilization. Scale bars: 100 µm. (b, c) Immunofluorescence staining of permeabilized MEF clones was performed with anti-type I collagen (green) and anti-KDEL antibodies (red) (b) or anti-type I collagen (green) and anti-GM130 antibodies (red). (c) Scale bars: 10 µm.

Immunofluorescence staining of extracellular and intracellular type I collagen. (a) Immunofluorescence staining of type I collagen secreted from MEF clones was performed with an anti-type I collagen antibody without cell permeabilization. Scale bars: 100 µm. (b, c) Immunofluorescence staining of permeabilized MEF clones was performed with anti-type I collagen (green) and anti-KDEL antibodies (red) (b) or anti-type I collagen (green) and anti-GM130 antibodies (red). (c) Scale bars: 10 µm.

Immunofluorescence staining of extracellular and intracellular type I collagen. (a) Immunofluorescence staining of type I collagen secreted from MEF clones was performed with an anti-type I collagen antibody without cell permeabilization. Scale bars: 100 µm. (b, c) Immunofluorescence staining of permeabilized MEF clones was performed with anti-type I collagen (green) and anti-KDEL antibodies (red) (b) or anti-type I collagen (green) and anti-GM130 antibodies (red). (c) Scale bars: 10 µm.

Immunohistochemistry of Anti-Collagen Type I. WT mice have significantly increased collagen type I expression in the tendon adhesions. Representative images of collagen type I expression (gold) in the tendon adhesions of WT (a-b) and FliiTg/Tg (e-f) mice and collagen type III expression (gold) in the tendon adhesions of WT (c-d) FliiTg/Tg (g-h) at 21 and 28 days post 50% partial laceration injury. (i) WT mice have significantly upregulated collagen type I levels in the adhesions compared with FliiTg/Tg mice. (j) No significant difference was noted in collagen type III levels in WT and FliiTg/Tg mice, although detectable levels of collagen type III were found in the FliiTg/Tg mice. DAPI is represented as blue fluorescence; t, tendon; d, dermis. Dotted line represents tendon adhesion area. Magnification × 10. Scale bar = 200 µm and refers to all images. Data represented as mean ± SEM. *p ≤ 0.05. n = 6.

Immunohistochemistry of Collagen I antibody. Tissue: human lung. Fixation: formalin fixed paraffin embedded. Antigen retrieval: user optimized. Primary antibody: Collagen 1 1:400 Secondary antibody: Peroxidase goat anti-rabbit at 1:10000 for 45 min at RT. Localization: Strong staining was observed in the extracellular matrix of the lung. Epithelial cells were negative. Staining: antibody as precipitated red signal with a hematoxylin purple nuclear counterstain.

Immunohistochemistry of Rabbit Anti-collagen type I antibody. Tissue: right lobe of the liver section. A: Central Vein (CV) fibrosis, B: Non-fibrotic CV, C: Perisinusodial fibrosis, D: Non-fibrotic area, E: Protat tract fibrosis, F: Septal fibrosis (arrow). Fixation: formalin fixed paraffin embedded. Antigen retrieval: not required. Primary antibody: Anti-collagen type I at 1:1250 for 4°C for 24hr. Secondary antibody: Peroxidase biotin-streptavidin rabbit secondary antibody at 1:10000 for 45 min at RT. Localization: Anti-collagen type I is intra and extracellular. Staining: 3.3'-diaminobenzidine tetrahydrochloride was used as the chromogen. Nuclei were counterstained purple with hematoxylin.

Immunohistochemistry results of Rabbit Anti-Collagen Type I Antibody. Tissue: human stomach mucosa (TMA). Fixation: FFPE. Antigen Retrieval: HIER using Tris-EDTA-citrate buffer pH7.8 for 5 min. Blocking: Peroxidase-Blocking Solution for 10 min. Primary Antibody: Anti-Collagen Type I (p/n orb345343) at 1:15 for 1 hr at 37 °C. Secondary Antibody: Dako REAL EnVision Detection Kit, Polymer-HRP, Rabbit/Mouse. Counterstain: Hematoxylin for 15 sec. Substrate: DAB-Chromogen, Rabbit/Mouse. Staining/Results: basement membranes and blood vessels.

Immunohistochemistry results of Rabbit Anti-Collagen Type I Antibody. Tissue: human stroma of a colorectal adenocarcinoma. Fixation: FFPE. Antigen Retrieval: HIER using Tris-EDTA-citrate buffer pH7.8 for 5 min. Blocking: Peroxidase-Blocking Solution for 10 min. Primary Antibody: Anti-Collagen Type I (p/n orb345343) at 1:15 for 1 hr at 37 °C. Secondary Antibody: Dako REAL EnVision Detection Kit, Polymer-HRP, Rabbit/Mouse. Counterstain: Hematoxylin for 15 sec. Substrate: DAB-Chromogen, Rabbit/Mouse. Staining/Results: Cancer cells are collagen I negative.

Immunohistochemistry results of Rabbit Anti-Collagen Type I Antibody. Tissue: human tubuli and blood vessels. Fixation: FFPE. Antigen Retrieval: HIER using Tris-EDTA-citrate buffer pH7.8 for 5 min. Blocking: Peroxidase-Blocking Solution for 10 min. Primary Antibody: Anti-Collagen Type I (p/n orb345343) at 1:15 for 1 hr at 37 °C. Secondary Antibody: Dako REAL EnVision Detection Kit, Polymer-HRP, Rabbit/Mouse. Counterstain: Hematoxylin for 15 sec. Substrate: DAB-Chromogen, Rabbit/Mouse. Staining/Results: Intense collagen I staining of fibres surrounding tubuli and around blood vessels.

Immunohistochemistry results of Rabbit Anti-Collagen Type I Antibody. Tissue: smooth muscle cells of human stomach wall. Fixation: FFPE. Antigen Retrieval: HIER using Tris-EDTA-citrate buffer pH7.8 for 5 min. Blocking: Peroxidase-Blocking Solution for 10 min. Primary Antibody: Anti-Collagen Type I (p/n orb345343) at 1:15 for 1 hr at 37 °C. Secondary Antibody: Dako REAL EnVision Detection Kit, Polymer-HRP, Rabbit/Mouse. Counterstain: Hematoxylin for 15 sec. Substrate: DAB-Chromogen, Rabbit/Mouse. Staining/Results: smooth muscle cells surrounded by collagen fibers.

Recombinant ACLP inhibits adipogenesis and enhances myofibroblast differentiation in human adipose stromal cells. A, Scheme of time course for adipogenesis of hASC. B, hASC derived from subcutaneous adipose depots were induced to undergo adipogenesis with CDM on day 0. Protein was harvested on days 0, +1, +2, +8 and +15. Protein expression was analyzed using SDS-PAGE and Western blot with antibodies against ACLP, α-SMA, FABP4 and cyclophilin-A. C, Omental hASC were induced to undergo adipogenesis with CDM on day 0. Protein was harvested on days 0, +1, +2, +8 and +15. Protein expression was analyzed using SDS-PAGE and Western blot with antibodies against ACLP, α-SMA, FABP4 and cyclophilin-A. D, Scheme of adipogenesis for hASC and rACLP treatment. E, Subcutaneous hASC were treated with 30 nM rACLP on days -2, -1 and 0 and induced to undergo adipogenesis with CDM on day 0 and +4. Protein was harvested on day + 15 and analyzed by SDS-PAGE and Western blot with antibodies against collagen, α-SMA, perilipin, FABP4 and CypA (n = 3). F, Subcutaneous hASC were treated with 30 nM rACLP on days -2, -1, and 0 and induced to undergo adipogenesis with CDM on day 0 and +4. On day +15 cells were fixed, stained, imaged and quantified with Oil Red O dye (n = 5). Data were normalized relative to control. * p < 0.05 versus control. Data presented are expressed as mean ± SD. The scale bar represents 2 mm.

Biorbyt's Affinity Purified anti-Collagen I antibody was used at a 1:100 dilution to detect distal tubules in normal kidney tissue. Note the absence of staining of glomeruli. The antibody was reacted with antibody for 4 hours at room temperature followed by the addition of secondary antibody and substrate reaction. Tissue was formalin-fixed and paraffin embedded. No antigen retrieval was performed.

The effect of ColQ1 on dermal COL of pig-skin. a, b) Quantification of Hyp release over time after treatment with different concentrations of a) B. cereus csn (0, àí100% v/v) and b) ColQ1 (0, àí500 √ó 10, àí9 M). This graph contains data adapted from our previous publication. [38] c) Confocal SHG Z-stack images of the COL structure in skin dermal region that was non-treated or treated with 300 √ó 10, àí9 M ColQ1. d) B. cereus ColQ1 (300 √ó 10, àí9 M) degraded the fibrillar COLs, immunostaining of non-treated and ColQ1 treated pig skin with COL antibodies (COL I, III, and V). COL: collagen, Hyp: hydroxyproline, B. cereus: Bacillus cereus, csn: culture supernatant, SHG: second harmonic generation. Data point represents mean value ¬± standard deviation (n = 3). Scale bar: 100 Œºm for SHG images and immunostained images.

Western blot analysis is shown using Biorbyt's Affinity Purified anti-Collagen I antibody to detect expression of collagen I in Wistar rat hepatic stellate cells (HSC) in control (GFP-transduced) (left lane) and PPARg-transduced cell lysates (right lane). Protein staining shown below each blot depicts equal protein loading. An equal amount of the whole cell protein (100 µg) was separated by SDS-PAGE and electroblotted to nitro-cellulose membranes. Proteins were detected by incubating the membrane with anti-Collagen I antibody at a concentration of 0.2–2 µg/10 ml in TBS (100 mM Tris-HCl, 0.15 M NaCl, pH 7.4) with 5% Non-fat milk. Detection occurred by incubation with a horseradish peroxidase-conjugated secondary antibody at 1 µg/10 ml. Proteins were detected by a chemiluminescent method using the PIERCE ECL kit. Other detection systems will yield similar results.

Western blot of Human Collagen Type I. Lane 1: Human Collagen Type 1 (p/n orb750381). Load: 50 ng per lane. Primary antibody: Collagen Type I antibody at 1:1000 overnight at 4°C. Secondary antibody: DyLight™ 649 rabbit secondary antibody at 1:20000 for 30 min at RT. Block: (p/n orb348637) for 30 min at RT. Predicted/Observed size: 139 & 130 kDa, 139 & 130 kDa for Collagen Type I. Other Band(s): Collagen Type I splice variants and isoforms.
Quick Database Links
UniProt Details
−NCBI Reference Sequences
−| Protein | NP_000079.2 |
|---|
Documents Download
Request a Document
Protocol Information
Collagen Type I Antibody (orb345344)
Participating in our Biorbyt product reviews program enables you to support fellow scientists by sharing your firsthand experience with our products.
Login to Submit a Review